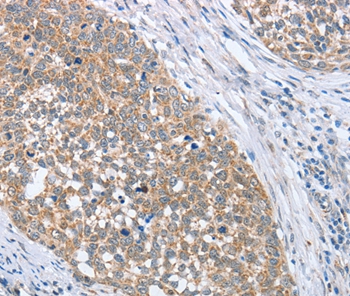

Immunofluorescence analysis of methanol-fixed HeLa, using PAPSS1(GTX103608) antibody at 1:200 dilution.
PAPSS1 antibody [C1C3]
GTX103608
ApplicationsImmunoFluorescence, Western Blot, ImmunoCytoChemistry, ImmunoHistoChemistry, ImmunoHistoChemistry Paraffin
Product group Antibodies
ReactivityHuman, Mouse
TargetPAPSS1
Overview
- SupplierGeneTex
- Product NamePAPSS1 antibody [C1C3]
- Delivery Days Customer9
- Application Supplier NoteWB: 1:500-1:3000. ICC/IF: 1:100-1:1000. IHC-P: 1:100-1:1000. *Optimal dilutions/concentrations should be determined by the researcher.Not tested in other applications.
- ApplicationsImmunoFluorescence, Western Blot, ImmunoCytoChemistry, ImmunoHistoChemistry, ImmunoHistoChemistry Paraffin
- CertificationResearch Use Only
- ClonalityPolyclonal
- Concentration0.94 mg/ml
- ConjugateUnconjugated
- Gene ID9061
- Target namePAPSS1
- Target description3'-phosphoadenosine 5'-phosphosulfate synthase 1
- Target synonymsATPSK1, PAPSS, SK1, bifunctional 3'-phosphoadenosine 5'-phosphosulfate synthase 1, 3-prime-phosphoadenosine 5-prime-phosphosulfate synthase 1, PAPS synthase 1, PAPSS 1, SK 1, adenylyl-sulfate kinase, sulfate adenylyltransferase, sulfurylase kinase 1
- HostRabbit
- IsotypeIgG
- Protein IDO43252
- Protein NameBifunctional 3'-phosphoadenosine 5'-phosphosulfate synthase 1
- Scientific DescriptionThree-prime-phosphoadenosine 5-prime-phosphosulfate (PAPS) is the sulfate donor cosubstrate for all sulfotransferase (SULT) enzymes (Xu et al., 2000 [PubMed 10679223]). SULTs catalyze the sulfate conjugation of many endogenous and exogenous compounds, including drugs and other xenobiotics. In humans, PAPS is synthesized from adenosine 5-prime triphosphate (ATP) and inorganic sulfate by 2 isoforms, PAPSS1 and PAPSS2 (MIM 603005).[supplied by OMIM]
- ReactivityHuman, Mouse
- Storage Instruction-20°C or -80°C,2°C to 8°C
- UNSPSC41116161

![PAPSS1 antibody [N1C1] detects PAPSS1 protein at cytosol on human gastric cancer by immunohistochemical analysis. Sample: Paraffin-embedded gastric cancer. PAPSS1 antibody [N1C1] (GTX107427) dilution: 1:500.
Antigen Retrieval: Trilogy? (EDTA based, pH 8.0) buffer, 15min](https://www.genetex.com/upload/website/prouct_img/normal/GTX107427/GTX107427_40408_IHC_2_w_23060120_359.webp)